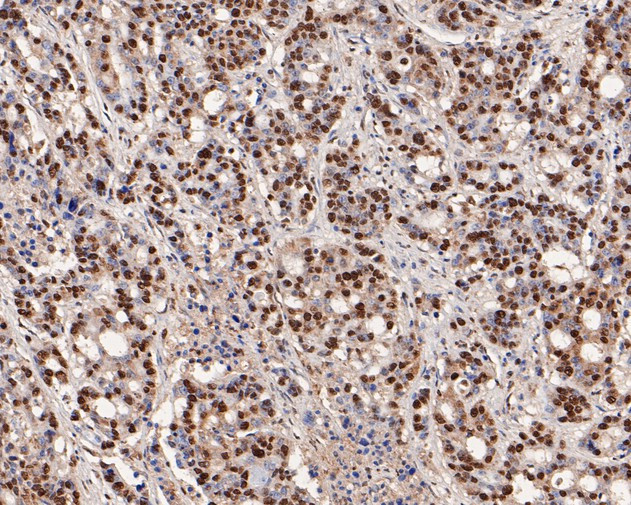
hnRNP L Antibody in Immunohistochemistry (Paraffin) (IHC (P))

Search
Huabio
hnRNP L Polyclonal Antibody
{{$productOrderCtrl.translations['antibody.pdp.commerceCard.promotion.promotions']}}
{{$productOrderCtrl.translations['antibody.pdp.commerceCard.promotion.viewpromo']}}
{{$productOrderCtrl.translations['antibody.pdp.commerceCard.promotion.promocode']}}: {{promo.promoCode}} {{promo.promoTitle}} {{promo.promoDescription}}. {{$productOrderCtrl.translations['antibody.pdp.commerceCard.promotion.learnmore']}}
图: 1 / 7
hnRNP L Antibody (HA500115) in IHC (P)







产品信息
HA500115
种属反应
宿主/亚型
分类
类型
抗原
偶联物
形式
浓度
规格
纯化类型
保存液
内含物
保存条件
运输条件
靶标信息
Heterogeneous nuclear RNAs (hnRNAs) which include mRNA precursors and mature mRNAs are associated with specific proteins to form heterogenous ribonucleoprotein (hnRNP) complexes. Heterogeneous nuclear ribonucleoprotein L is among the proteins that are stably associated with hnRNP complexes and along with other hnRNP proteins is likely to play a major role in the formation, packaging, processing, and function of mRNA. Heterogeneous nuclear ribonucleoprotein L is present in the nucleoplasm as part of the HNRP complex. HNRP proteins have also been identified outside of the nucleoplasm. Exchange of hnRNP for mRNA-binding proteins accompanies transport of mRNA from the nucleus to the cytoplasm. Since HNRP proteins have been shown to shuttle between the nucleus and the cytoplasm, it is possible that they also have cytoplasmic functions. Two transcript variants encoding different isoforms have been found for this gene.
仅用于科研。不用于诊断过程。未经明确授权不得转售。
篇参考文献 (0)
生物信息学
蛋白别名: epididymis secretory sperm binding protein; FLJ35509; Heterogeneous nuclear ribonucleoprotein L; hnRNP L; unnamed protein product
基因别名: hnRNP-L; HNRNPL; HNRPL; P/OKcl.14
UniProt ID: (Human) P14866
Entrez Gene ID: (Human) 3191